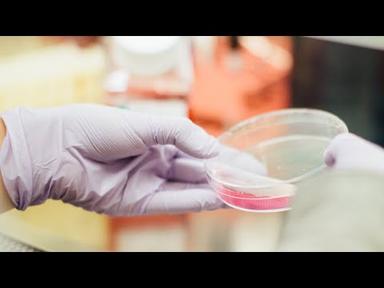

Video: Are fibroids cancerous?
Peer reviewed by Dr Krishna Vakharia, MRCGPLast updated by Lydia SmithLast updated 2 Aug 2023
Meets Patient’s editorial guidelines
- DownloadDownload
- Share
- Language
- Discussion
Any growth in your womb can be worrying, but fibroids are generally not a cause for major concern. However, they can lead to many questions - which our expert Dr Sarah Jarvis has answered below.
In this article:
Video picks for General women's health
Playlist: Fibroids Q&A
9 videos
Are fibroids cancerous?
Dr Sarah Jarvis MBE, FRCGP
Are fibroids cancerous?
Dr. Sarah Jarvis MBE, FRCGP

Can fibroids cause miscarriages?
Dr. Sarah Jarvis MBE, FRCGP

Can fibroids cause infertility?
Dr. Sarah Jarvis MBE, FRCGP

How many fibroids is too many?
Dr. Sarah Jarvis MBE, FRCGP

How many fibroids can a woman have?
Dr. Sarah Jarvis MBE, FRCGP

How are fibroids removed?
Dr. Sarah Jarvis MBE, FRCGP

How much can fibroids grow?
Dr. Sarah Jarvis MBE, FRCGP

Do fibroids shrink after menopause?
Dr. Sarah Jarvis MBE, FRCGP

Do fibroids bleed?
Dr. Sarah Jarvis MBE, FRCGP
Are fibroids cancerous?
Fibroids are growths of the muscle that lines the womb, but they are not cancerous nor do they ever turn into cancer. In fact, around two in three women who have fibroids never even know that they have them.
Can fibroids cause miscarriages?
Back to contentsOften, fibroids and miscarriages aren’t connected. Occasionally, however, fibroids may reduce the amount of blood supply to an embryo or make it difficult for that embryo to implant and grow, which can lead to a miscarriage.
Continue reading below
Can fibroids cause infertility?
Back to contentsFibroids are really common. Around one in four women get them at some stage and in the vast majority of cases, they don’t cause fertility problems. Sometimes, though, fibroids can stop sperm from being able to get into the womb effectively.
Sometimes they can block the entrance to the fallopian tubes which is where the fertilised egg comes down in order to get into the womb. And in some cases, especially if you have lot of fibroids, it can make it difficult for that fertilised egg to find anywhere to implant in your womb and start to grow.
How many fibroids is too many?
Back to contentsFibroids are benign and non-cancerous growth of the womb. You can have either one or you can have many. However, there is no real definition of how many is too many, because one women might have one large fibroid which cause severe problems - while other women may have dozens of tiny fibroids which don’t cause any symptoms.
Continue reading below
How many fibroids can a woman have?
Back to contentsFibroids are non-cancerous growths of the womb, specifically, the muscle that lines the womb. You can have dozens of them and they very much depend in terms of how many problems they cause, on their size.
Many women will have dozens of tiny almost pea sized growths and they won’t cause any symptoms at all, where some women will have one very large fibroid that can distort the cavity of the womb or grow outside the womb which can cause heavy bleeding, pain and sometimes other problems.
How are fibroids removed?
Back to contentsThere are several treatments for fibroids which include medical treatments, tablets, hormones and surgical treatments. Some treatments don’t remove the fibroids, but shrink them instead. One of these is called uterine artery embolisation where the blood supply to the fibroids is cut off, so that it withers and fades away.
Another is called MRI focus ultrasound where high powered beams of ultrasound are directed at the fibroids using MRI control. Alternatively, key hole surgery or in the case of bigger fibroids, open surgery where the wall of the stomach is cut open, can be used to remove the fibroids. This is called myomectomy. As a last resort, and these days not very often done is hysterectomy, where the whole womb is removed.
How much can fibroids grow?
Back to contentsThere is a huge variation in the possible size of fibroids. Some women have lots of very small fibroids even as small as a pea. In some women however one single fibroid can grow very large . Very large fibroids can lead to symptoms including bloating, pressure on the bladder or bowel - and it can affect your fertility and lead to heavy or painful periods.
Do fibroids shrink after the menopause?
Back to contentsFibroids largely depend on the hormone oestrogen in order to grow. Therefore, they tend to be most problematic for women in their early 20s until the menopause. After the menopause, these fibroids will almost always shrink. They may not disappear completely but they certainly shouldn’t cause problems in most people. But the only exception is if you take hormone treatment like HRT which contains oestrogen, so this can keep the fibroids going.
Do fibroids bleed?
Back to contentsThe most common symptom is heavy - and sometimes painful - periods. Usually fibroids do not cause bleeding between your periods. If you do get irregular bleeding between your periods or bleeding after the menopause you should always get it checked out.
Patient picks for General women's health

Women's health
Should vaginal mesh surgery be banned?
When Kath Sansom first went to her GP, worried about incontinence, she was a fit and active mother of two teenage daughters who, like many women of a certain age, had started to experience embarrassing leaks during exercise. "I was referred to a consultant, and the vaginal mesh operation was very much sold to me as a quick and simple fix. I was told I'd be a day case, out in 20 minutes, home in time for tea, and back at my desk in a week," she explains. In reality though, Sansom says she came out in so much pain she could hardly walk - and she's not the only one.
by Sarah Graham

Women's health
Spotting the signs of fibroids
Many women develop fibroids at some point in their lives - often between the ages of 30 and 50. They are surprisingly common, and affect up to two-thirds of women. Fibroids can sometimes run in families, so if a close relative has them, you may be more likely to as well. When Adrienne Noble - an artist from Whithorn, Scotland - was first diagnosed, she knew nothing about fibroids. She only knew she was experiencing pain and heavy periods, which she put down to simply getting older. It took two years before she finally discovered not only that she had fibroids but that she needed immediate surgery.
by Victoria Raw
Continue reading below
Article history
The information on this page is peer reviewed by qualified clinicians.
Next review due: 2 Aug 2026
2 Aug 2023 | Latest version
18 Mar 2018 | Originally published
Authored by:
Dr Sarah Jarvis MBE, FRCGP

Ask, share, connect.
Browse discussions, ask questions, and share experiences across hundreds of health topics.
Feeling unwell?
Assess your symptoms online for free
Sign up to the Patient newsletter
Your weekly dose of clear, trustworthy health advice - written to help you feel informed, confident and in control.
By subscribing you accept our Privacy Policy. You can unsubscribe at any time. We never sell your data.